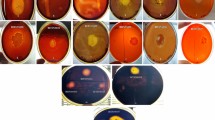

Abstract
Genetic screening at temperatures between 70–80°C far exceeds the range of growth of most bacteria, and is not applicable to isolate easily thermostable protein variants. We describe a temperature shift protocol and an in vivo screening method which allowed us to identify a hyperthermostable variant of the thermostable α-amylase from Bacillus licheniformis. Our strategy was to select, after hydroxylamine mutagenesis, an intragenic suppressor mutation which overcomes a mutation leading to a thermolabile enzyme. Sequence analysis of the mutated gene revealed only one change in the amino acid sequence, substituting a valine for alanine at position 209. This single amino acid replacement increased the half-life of the protein at 90°C by a factor of two to three relative to the wild-type enzyme. When this substitution was combined with another stabilizing substitution (H133Y) we described previously, the stabilizing effects were additive. The half-life of the new protein was about 12 hours at 90°C, corresponding to a nine to ten-fold increase over the wild-type enzyme and the industrial Bacillus licheniformis α-amylase Termamyl®. These mutations are located in a predicted folding domain of the protein which appears crucial in determining thermal stability.
This is a preview of subscription content, access via your institution
Access options
Subscribe to this journal
Receive 12 print issues and online access
$259.00 per year
only $21.58 per issue
Buy this article
- Purchase on SpringerLink
- Instant access to the full article PDF.
USD 39.95
Prices may be subject to local taxes which are calculated during checkout
Similar content being viewed by others
References
Yuuki, T., Nomura, T., Tezuka, H., Tsuboi, A., Yamagata, H., Tsukagoshi, N. and Udaka, S. 1985. Complete nucleotide sequence of a gene coding for heat- and pH-stable α-amylase of Bacillus licheniformis: Comparison of the amino acid sequences of the three bacterial liquefying α-amylase deduced from the DNA sequences. J. Biochem. 98: 1147–1156.
Matsumura, M., Becktel, W.J., Levitt, M. and Matthews, B.W. 1989. Stabilization of phage T4 lysozyme by engineered disulfide bonds. Proc. Natl. Acad. Sci. USA 86: 6562–6566.
Wetzel, R., Perry, L.J., Baase, W.A. and Becktel, W. 1988. Disulfide bonds and thermal stability in T4 lysosyme. Proc. Natl. Acad. Sci. USA 85: 401–405.
Pantoliano, M.W., Ladner, R.C., Bryan, P.N., Rollence, M.L., Wood, J.F. and Poulos, T.L. 1987. Protein engineering of subtilisin BPN′: enhanced stabilization through the introduction of two cysteines to form a disulfide bond. Biochemistry 26: 2077–2082.
Sauer, R.T., Hehir, K., Stearman, R.S., Weiss, M.A., Jeitler-Nilsson, A., Suchanek, E.G. and Pabo, C.O. 1986. An engineered intersubunit disulfide enhances the stability and DNA binding of the N-terminal domain of lambda represser. Biochemistry 25: 5992–5998.
Nicholson, H., Becktel, W.J. and Matthews, B.W. 1988. Enhanced protein thermostability from designed mutations that interact with α-helix dipoles. Nature 336: 651–656.
Hecht, M.H., Sturtevant, J.M. and Sauer, R.T. 1986. Stabilization of lambda represser against thermal denaturation by site-directed Gly/Ala changes in α-helix 3. Proteins Struct. Funct. Genet. 1: 43–46.
Bryan, P.N., Rollence, M.L., Pantoliano, M.W., Wood, J., Finzel, B.C., Gilliland, G.L., Howard, A.J. and Poulos, T.L. 1986. Proteases of enhanced stability: characterization of a thermostable variant of subtilisin. Proteins Struct. Funct. Genet. 1: 326–334.
Imanaka, T., Shibazaki, M. and Takagi, M. 1986. A new way of enhancing the thermostability of proteases. Nature 324: 695–697.
Quax, W.J., Mrabet, N.T., Luiten, R.G.M., Schuurhuizen, P.W., Stanssens, P. and Lasters, I. 1991. Enhancing the thermostability of glucose isomerase by protein engineering. Bio/Technology 9: 738–742.
Argos, P., Rossmann, M.G., Grau, U.M., Zuber, H., Frank, G. and Trat-schin, J.D. 1979. Thermal stability and protein structure. Biochemistry 18: 5698–5703.
Declerck, N., Joyet, P., Gaillardin, C. and Masson, J.-M. 1990. Use of amber suppressors to investigate the thermostability of Bacillus licheniforrnis α-amylase. J. Biol. Chem. 265: 15481–15488.
Matsumura, M. and Aiba, S. 1985. Screening for thermostable mutants of kanamycin nucleotidyltransferase by the use of a transformation system for a thermophile, Bacillus stearothermophilus . J. Biol. Chem. 260: 15298–15303.
Liao, H., McKenzie, T. and Hageman, R. 1986. Isolation of a thermostable enzyme variant by cloning and selection in a thermophile. Proc. Natl. Acad. Sci. USA 83: 576–580.
Shortle, D. and Lin, B. 1985. Genetic analysis of staphilococcal nuclease: identification of three intragenic “global” suppressors of nuclease-minus mutation. Genetics 110: 539–555.
Das, G., Hickey, D.R., McLendon, D., McLendon, G. and Sherman, F. 1989. Dramatic thermostabilization of the yeast iso-1-cytochrome c by an asparagine/isoleucine replacement at position 57. Proc. Natl. Acad. Sci. USA 86: 496–499.
Pakula, A.A. and Sauer, R.T. 1989. Amino acids substitutions that increase the thermal stability of the lambda Cro protein. Proteins Struct. Funct. Genet. 5: 202–210.
Suzuki, Y., Ito, N., Yuuki, T., Yamagata, H. and Udaka, S. 1989. Amino acid residues stabilizing a Bacillus α-amylase against irreversible thermoinactivation. J. Biol. Chem. 264: 18933–18938.
Vihinen, M., Ollikka, P., Niskanen, J., Meyer, P., Suominen, I., Karp, M., Holm, L., Knowles, J. and Mäntsälä, P. 1990. Site-directed mutagenesis of a thermostable α-amylase from Bacillus stearothermophilus: Putative role of three conserved residues. J. Biochem. 107: 267–272.
Alber, T. and Wozniak, J.A. 1985. A genetic screen for mutations that increase the thermal stability of phage T4 lysozyme. Proc. Natl. Acad. Sci. USA 82: 747–750.
Matsumura, M., Yasumura, S. and Aiba, S. 1986. Cumulative effect of intragenic amino-acid replacements on the thermostability of a protein. Nature 323: 356–358.
Matsumura, M., Signor, G. and Matthews, B.W. 1989. Substantial increase of protein stability by multiple disulphide bonds. Nature 342: 291–293.
Matsuura, Y., Kusunoki, M., Harada, W. and Kakudo, M. 1984. Structure and possible catalytic residues of Taka-amylase A. J. Biochem. 95: 697–702.
Buisson, G., Duée, E., Haser, R. and Payan, F. 1987. Three dimensional structure of porcine pancreatic α-amylase at 2.9 Å resolution. Role of calcium in structure and activity. EMBO J. 6: 3909–3916.
Holm, L., Koivula, A.K., Lehtovaara, P.M., Hemminki, A. and Knowles, J.K.C. 1990. Random mutagenesis used to probe the structure and function of B. stearothermophilus α-amylase. Protein Eng. 3: 181–191.
Phillips, D.C., Sternberg, M.J.E., Thornton, J.M. and Wilson, I.A. 1978. An analysis of the structure of triose phosphate isomerase and its comparison with lactate deshydrogenase. J. Mol. Biol. 119: 329–351.
Raimbaud, E., Buleon, A., Perez, S. and Henrissat, B. 1989. Hydrophobic cluster analysis of the primary sequences of α-amylases. Int. J. Biol. Macromol. 11: 217–225.
Tomazic, S.J. and Klibanov, A.M. 1988. Why one Bacillus amylase is more resistant against irreversible thermoinactivation than another? J. Biol. Chem. 263: 3092–3096.
Tomazic, S.J. and Klibanov, A.M. 1988. Mechanisms of irreversible thermal inactivation of Bacillus α-amylases. J. Biol. Chem. 263: 3086–3091.
Gray, G.L., Mainzer, S.E., Rey, M.W., Lamsa, M.H., Kindle, K. L., Carmona, C. and Requadt, C. 1986. Structural gene encoding the thermophilic α-amylases of Bacillus stearothermophilus and Bacillus licheniformis . J. Bacteriol. 166: 635–643.
Tessmann, I. 1968. Mutagenic treatement of double and single stranded DNA phages T4 and S13 with hydroxylamine. Virology 35: 330–338.
Neu, H., and C., Heppel, L., A. 1965. The release of enzymes from Escherichia coli by osmotic shock and during the formation of spheroplasts. J. Biol. Chem. 240: 3685–3692.
Bernfeld, P., 1955. Amylases, α and β . Methods in Enzymol. 1: 149–158.
Author information
Authors and Affiliations
Rights and permissions
About this article
Cite this article
Joyet, P., Declerck, N. & Gaillardin, C. Hyperthermostable Variants of a Highly Thermostable Alpha-Amylase. Nat Biotechnol 10, 1579–1583 (1992). https://doi.org/10.1038/nbt1292-1579
Received:
Accepted:
Issue date:
DOI: https://doi.org/10.1038/nbt1292-1579
This article is cited by
-
Rational design and structure-based engineering of alkaline pectate lyase from Paenibacillus sp. 0602 to improve thermostability
BMC Biotechnology (2021)
-
Metabolite-based mutualism enhances hydrogen production in a two-species microbial consortium
Communications Biology (2019)
-
Structure Prediction of a Novel Exo-β-1,3-Glucanase: Insights into the Cold Adaptation of Psychrophilic Yeast Glaciozyma antarctica PI12
Interdisciplinary Sciences: Computational Life Sciences (2018)
-
Structure-based engineering of alkaline α-amylase from alkaliphilic Alkalimonas amylolytica for improved thermostability
Applied Microbiology and Biotechnology (2014)
-
Sequence and structural investigation of a novel psychrophilic α-amylase from Glaciozyma antarctica PI12 for cold-adaptation analysis
Journal of Molecular Modeling (2013)